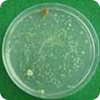

面向未来的企业
作为综合贸易与综合流通产业的国际领导者走向世界市场
天然 抗菌母粒
BioCleanAct™ 天然植物提取物抗菌塑料母料是使用 MST股份有限公司的专业技术开发并制作成颗粒状的抗菌新材料。运用于各种塑料制品,并且对人体无害的同时对各种有害细菌及霉菌等有优秀显著的抗菌效果。BioCleanAct™ 抗菌塑料母料加工性优秀并且和众多材料相溶性良好,添加于 LDPE,PVC,SAN,PP,ABS,PET, Nylon,PC,TPE,PS,PU,TPU,Polyester chip等中经过吹塑、压塑、喷塑成型等加工。运用于卫生生活用品、食品包装材料、医疗用品、家电用品、汽车内部装修材料、特殊军需用品、用於嬰幼兒用品等多種用途的抗菌源泉技術新材料。

Polyester Chip (抗菌,防臭,潮湿,负离子,微波遮挡,红外线散射机能性,纤维纺纱用)-特殊军需用。

- 人体经口无毒性,皮肤无刺激性,环境无毒性。
- 未检测出环境荷尔蒙
- 保证抗细菌,抗霉菌效果(保证在世界抗菌材料中唯一的抗菌技术材料)
- 保证持久的抗菌效果(保证在世界抗菌材料中唯一的抗菌技术材料)
- 卓越的光和热安全性
- 以美国FDA及韩国FDA规定为标准取得所有公认实验报告。(人体安全性,抗菌效果,环境性,溶出性等)
- EU/REACH(169 SVHC)

产品 代码 号码 |
基托树脂 | 适用树脂 | 效能保证 添加量(%) | 适用产品 | 生产方法 |
BCA-502MBN | LDPE | LLDPE LDPE HDPE PP |
添加 5% 以上 |
细菌成为问题的洗衣机、空调机等电子产品、医疗用品、生活用品、婴儿用品、洗浴用品、瓶盖、食品器皿、空调过滤器、工业用品、汽车内装材料、特殊军需品(潜艇、舰艇蓄水槽)、军用水壶、自来水管、便携式抗菌水壶、汽车内装材料、净水器、空气过滤器、汽车过滤器布料纺丝用 |
射出, 压出 |
添加 7% 以上 |
食品包装材料, 购物袋, 涂塑纸用薄膜 (PET, 尼龙等) | 薄膜 , 吹塑 | |||
隔离纸, 防湿纸, 软包装 等 | 层压 | ||||
BCA-503MBN | PVC | PVC |
添加 5% 以上 |
医疗用品,工业用品,汽车配件等,电子配件 |
射出, 压出 |
BCA-504MBN | SAN | SAN |
添加 5% 以上 |
电子产品, 生活用品, 幼儿用品, 汽车配件等 | 射出, 压出 |
BCA-505MBN | PP | PP |
添加 5% 以上 |
细菌成为问题的吸管、医疗箱等。 | 压出 |
净水器, 特殊军用产品(潜水艇, 潜艇水槽), 军用水桶 , 空调, 家电产品, 生活用品, 汽车配件, 建筑内装材料等 | 射出 | ||||
添加 7% 以上 |
CPP 薄膜 , 蒸着用薄膜 , 吹塑等 | 薄膜 , 吹塑 | |||
BCA-506MBN | ABS | ABS | 添加 5% 以上 | 电子产品, 生活用品, 幼儿用品, 汽车配件等 | 射出,压出 |
BCA-507MBN | PET | PET | 添加 5%~7% 以上 |
医用长纤维, 功能性长纤维, staple fiber, 功能性 薄膜, 各种器皿 |
射出,压出,纺花,吹塑 |
BCA-508MBN | Nylon | Nylon | 添加 5%~7% 以上 | 長纖維、功能性纖維、人造草坪 人造地毯、功能性薄膜等 | 射出,压出,纺花,吹塑 |
BCA-509MBN | PC | PC |
添加 7%~10% 以上 |
家用电器(洗衣机、冰箱等)、隔音墙、移动设备等 | 射出,压出 |
抗菌复合物 |
■ 可以依据订单生产供应抗菌复合物 ■ 最少订货量:10吨以上 |
||||
另外 包括橡胶、聚氨酯的所有塑料抗菌母粒的最低订货量为1吨以上时,可制造并供应 |
|||||
抗菌-抗静电功能性母粒订货量为1吨以上时,可另制造并供应 |
|||||
但是,在第一次,当客户提供采样制造用所需树脂时,可少量制造并提供样品 |
- 包装单位 : 25kg (Paper bag)
-
参考事项 :
我公司生产的抗菌母粒全部产品会随着制造工程、生产工人、作业温度、作业季节、工厂湿度、生产线机械等的
差异,每批号产品的颜色会有些明显差异,但是对抗菌功能没有影响,所以可以放心使用。


- 加拿大马尼托巴州立大学共同研究
- 仁荷大学BK21项目共同研究
- ISO 9001 (澳洲, 新西兰公认)
- FDA cGLP 公认试验机关
- KFDA 公认试验机关 (韩国化学试验研究院)
- 申请、取得韩国国内, 海外专利
◎ 抗菌塑料母料效能检查演示(各种菌株)
-
1 . 抗细菌检查演示
黄色葡萄球菌 大肠菌 沙门氏菌 肺炎肝菌 军团菌 绿脓菌 枯草菌 芽孢杆菌 -
2 . 抗霉菌检查演示
黑霉菌 绿霉菌 假丝酵母菌 Trychophton 藓菌
特别对冷房医院原因菌军团菌有特效,除此之外,对细菌株也有优秀的效果.
BioCleanAct™ 天然植物提取物抗菌塑料母料是使用 MST股份有限公司的专业技术开发并制作成颗粒状的抗菌新材料。运用于各种塑料制品,并且对人体无害的同时对各种有害细菌及霉菌等有优秀显著的抗菌效果。BioCleanAct™ 抗菌塑料母料加工性优秀并且和众多材料相溶性良好,添加于 LLDPE,PVC,SAN,PP,ABS,PET, Nylon,PC,TPE,PS,PU,TPU,Polyester chip等中经过吹塑、压塑、喷塑成型等加工。运用于卫生生活用品、食品包装材料、医疗用品、家电用品、汽车内部装修材料、特殊军需用品、用於嬰幼兒用品等多種用途的抗菌源泉技術新材料。
专例现况
-
取得美国抗菌新物质专例 -
取得韩国抗菌新物质专例 -
取得中国抗菌新物质专例
商标注册
-
KOREA -
CHINA -
CHINA
公认成绩书
** 取得其他 US FDA 及 KFDA Food contect point诸多规定的所有关联实验成绩书的抗菌塑料母粒. **
-
US FDA 公认机关(毒性实验) -
US FDA 公认机关(抗菌实验) -
US FDA 公认机关(溶出实验) -
Korea FDA 公认机关 (急性口服毒性) -
Korea FDA 公认机关 (湧出试验) -
Korea FDA 公认机关 (有害物质) -
Korea FDA 公认机关 (抗细菌实验(1)) -
KTR公认机关 (抗细菌实验(2)) -
KTR公认机关(抗霉菌实验) -
REACH检测报告 (SVHC169种物质没有检出) -
环境激素实验成绩表 -
抗病毒公認試驗成績表
-甲型流感病毒(H1N1)
-冠状病毒
论文现况
** 除此之外,MST的抗菌新物质及新素材在外国的国际关联学术刊物(SCI)上发表了很多篇。**
-
外国国际学术刊物(SCI) 抗菌新素 材发表论文 -
外国国际学术刊物(SCI) 抗菌新素 材发表论文 -
外国国际学术刊物(SCI) 抗菌新素 材发表论文
BioCleanAct™ 天然植物提取物抗菌塑料母料是使用 MST股份有限公司的专业技术开发并制作成颗粒状的抗菌新材料。运用于各种塑料制品,并且对人体无害的同时对各种有害细菌及霉菌等有优秀显著的抗菌效果。BioCleanAct™ 抗菌塑料母料加工性优秀并且和众多材料相溶性良好,添加于 LLDPE,PVC,SAN,PP,ABS,PET, Nylon,PC,TPE,PS,PU,TPU,Polyester chip等中经过吹塑、压塑、喷塑成型等加工。运用于卫生生活用品、食品包装材料、医疗用品、家电用品、汽车内部装修材料、特殊军需用品、用於嬰幼兒用品等多種用途的抗菌源泉技術新材料。
应用事例
-
幼儿用抗菌拉链袋 -
抗菌湿巾 包装材 -
幼儿抗菌玩具类 -
食品包装用抗菌薄膜 -
食品用抗菌包装容器 -
食品用包装膜 -
军需用抗菌-除臭机能性菜板 (性能认证产品) -
短纤维 -
无纺布 -
医疗用口罩 -
空气过滤罩 -
净水用过滤膜 -
汽车过滤网用PE抗菌无纺布纺丝用 -
汽车内部装修抗菌材料 -
汽车方向盘等抗菌塑料喷出品 -
陈列用抗菌餐具,水壶 -
舰艇,潜艇净水淡水化抗菌过滤水箱 -
蓄水箱 -
电脑抗菌键盘 -
手机抗核辐射外壳 -
手机抗核辐射外壳 -
马桶座便器 -
加湿器 -
除湿器 -
空调系统 -
空调机 -
涂料槽 -
餐具干燥台 -
母乳储存袋 -
抗菌水管 -
抗菌无纺布 -
抗菌长纤维
适用案例、效果试验示例
“00”公司净水器用水槽
-
PP 材料里添加 BCA-502MB 3%后射出成型 (170℃∼190℃) 的水箱试片的抗细菌效果
大肠菌 沙门氏菌 肺炎杆菌 - 一定时期后从各净水器各采取10ml水样,在细菌培养皿培养4日。(unit : CFU/ml)
- * : 安装了添加有BioCleanAcTMt净水槽的净水器
食品医药品安全厅告示 饮用水一般细菌 许可标准 : 100 CFU / ㎖ 以下。

A:BioCleanAct™ 适用净水器(‘00’社净水器)- 细菌未检出
B:在一般净水器内检出细菌
“S” 公司抗菌薄膜




“D” 公司肉加工包装材料




“C”, “D” 公司抗菌菜板




BioCleanAct™ 天然植物提取物抗菌塑料母料是使用 MST股份有限公司的专业技术开发并制作成颗粒状的抗菌新材料。运用于各种塑料制品,并且对人体无害的同时对各种有害细菌及霉菌等有优秀显著的抗菌效果。BioCleanAct™ 抗菌塑料母料加工性优秀并且和众多材料相溶性良好,添加于 LLDPE,PVC,SAN,PP,ABS,PET, Nylon,PC,TPE,PS,PU,TPU,Polyester chip等中经过吹塑、压塑、喷塑成型等加工。运用于卫生生活用品、食品包装材料、医疗用品、家电用品、汽车内部装修材料、特殊军需用品、用於嬰幼兒用品等多種用途的抗菌源泉技術新材料。
-
取得美国抗菌新物质专例 -
取得韩国抗菌新物质专例 -
取得中国抗菌新物质专例 -
US FDA 公认机关(毒性实验) -
US FDA 公认机关(抗菌实验) -
US FDA 公认机关(溶出实验)